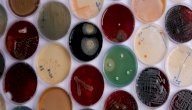
صورة مقال الأهمية الاقتصادية للكائنات الحية الدقيقة

محتويات

استخدامات التلسكوب
وفيما يأتي أبرز أنواع التلسكوبات واستخدامات كل منها:
استخدامات التلسكوبات البصرية
التلسكوبات البصرية هي عبارة عن عواكس، حيث إنها تقوم بتجميع الضوء المرئي، وتُستخدم في الوقت الحالي من قبل الهواة؛ في معرفة عدد من التفاصيل الموجودة داخل النظام الشمسي؛ كالحلقات حول الكواكب، وسطح القمر، كما وتُساعدهم أيضًا في رصد ودراسة عدد من النجوم والأجرام السماوية.[١]
استخدامات التلسكوبات الراديوية
تبدو التلسكوبات الراديوية وكأنها أطباق أقمار صناعية، وذلك لكونها تؤدي وظيفة واحدة وهي؛ تجميع وتركيز موجات الراديو والموجات الدقيقة القادمة من الفضاء، ومن الممكن أن يتم ربط مجموعة من هذه التلسكوبات مع جهاز كمبيوتر واحد بحيث تعمل جميعها كتلسكوب واحد.[١]
كما تُستخدم التلسكوبات الراديوية من قبل علماء الفلك لمراقبة الموجات الراديوية الطبيعية القادمة من المجرات، والكواكب، والنجوم، وجزيئات الغاز، وسحب الغبار.[٢]
استخدامات التلسكوبات الفضائية
توجد التلسكوبات الفضائية في الفضاء أي تمتلك القدرة على جمع وتحليل الإشعاع المنبعث من كل ما هو موجود في الفضاء وبجميع نطاقات الطيف الكهرومغناطيسي، والمراصد الموجودة في الفضاء مصممة لإجراء الدراسات الفلكية؛ اعتمادًا على عدد من الأطوال الموجية؛ المرئية، والأشعة تحت الحمراء، وأشعة غاما، والأشعة السينية.[٣]
أشهر الأمثلة على التلسكوبات
فيما يأتي أشهر التلسكوبات واستخدامات كل منها حول العالم:[٤]
- تلسكوب هابل الفضائي (HST)
يعمل تلسكوب هابل على توفير بيانات عالية في الدقة؛ يتم استخدامها في فهم مكونات المجرات الداخلية، وفي تمييز مصادر الضوء الصادرة عن النجوم أو عن الثقوب السوداء، كما ويتميز بكونه ذا حساسية عالية تمكنه من رؤية المجرات البعيدة والخافتة.
- تلسكوب سبيتزر الفضائي
يساعد تلسكوب سبيتزر العلماء في رؤية واكتشاف المناطق الكونية المخفية عن التلسكوبات البصرية؛ كمراكز المجرات، ومناطق الحضانات النجمية المتربة، وأيضًا يتيح رؤية ضوء النجوم في المجرات الموجودة على حافة الكون.
- تلسكوب هيرشل
تساعد البيانات التي يوفرها هيرشل العلماء على اكتشاف أصل وكيفية تطور النجوم والمجرات.
- تلسكوب مستكشف تطور المجرات (GALEX)
يساعد (GALEX) العلماء في اكتشاف أسباب تكون النجوم، وكيفية تكون المجرات وتطورها؛ حيث إن المجرات هي الهياكل الأساسية للكون.
- XMM- نيوتن وشاندرا
يساعد كل من XMM- نيوتن، وشاندرا العلماء على اكتشاف أماكن تواجد الثقوب السوداء، وأيضًا على رؤية الغاز الساخن في مجموعات المجرات.
- مصفوفة كارل جي بالغة الكبر (J-VLA)
تساعد مصفوفة كارل جي بالغة الكبر العلماء على فحص الثقوب السوداء، وتكوين النجوم.
- تلسكوبات كيك
تساعد تلسكوبات كيك العلماء على دراسة الأجسام الفردية.
- تلسكوب ألما
يساعد تلسكوب ألما العلماء على اكتشاف نشأة النجوم، بالإضافة إلى توفير الصور التفصيلية للنجوم المحلية، وبنية الكواكب.
التلسكوب
التلسكوب؛ أحد أهم الأدوات الاستقصائية في علم الفلك، يُستخدم لتكوين صور مُكبرة للأجسام البعيدة الموجودة في جميع أرجاء الكون، حيث إنه وسيلة لجمع وتحليل الإشعاع من مختلف الأجرام السماوية.[٥]
استُخدم التسلكوب لأول في دراسة الاجسام الموجودة خارج الأرض من قبل جاليليو، وذلك في أوائل القرن الـ17، الأمر الذي أحدث ثورة في علم الفلك، تواصل بعدها العمل على تطوير التلسكوبات البصرية، وجعلها أكثر قوةً، وبشكلٍ أساسي تم تعزيز قدرتها على الرصد، وقد ساعدت جميع المعلومات التي تقدمها على التقدم في المعرفة العلمية بالكون ككل.[٥]
المراجع
- ^ أ ب "Telescopes", lumen earth science , Retrieved 1/2/2022. Edited.
- ↑ "The Science of Radio Astronomy", The National Radio Astronomy Observatory, Retrieved 1/2/2022. Edited.
- ↑ "NASA's Great Observatories", nasa, Retrieved 1/2/2022. Edited.
- ↑ "Telescopes Used", cosmos, Retrieved 1/2/2022. Edited.
- ^ أ ب Kenneth I. Kellermann , "telescope", britannica, Retrieved 1/2/2022. Edited.